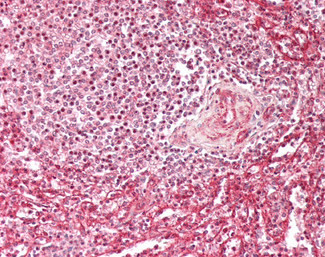
IFITM3 Antibody in Immunohistochemistry (Paraffin) (IHC (P))

Search
Invitrogen
IFITM3 Polyclonal Antibody
{{$productOrderCtrl.translations['antibody.pdp.commerceCard.promotion.promotions']}}
{{$productOrderCtrl.translations['antibody.pdp.commerceCard.promotion.viewpromo']}}
{{$productOrderCtrl.translations['antibody.pdp.commerceCard.promotion.promocode']}}: {{promo.promoCode}} {{promo.promoTitle}} {{promo.promoDescription}}. {{$productOrderCtrl.translations['antibody.pdp.commerceCard.promotion.learnmore']}}
产品信息
PA5-143273
种属反应
宿主/亚型
分类
类型
抗原
偶联物
形式
浓度
规格
纯化类型
保存液
内含物
保存条件
运输条件
RRID
产品详细信息
Additional Information: The immunizing peptide only differs by one residue from IFITM2 and therefore cross-reactivition of this antibody is to be expected.
This antibody is tested in Peptide ELISA: antibody detection limit dilution 1:64,000.
靶标信息
IFITM3 (interferon induced transmembrane protein 3), also known as 1-8U or IP15, is a multi-pass membrane protein that belongs to the IFITM (interferon inducible transmembrane) family of proteins. IFITM proteins are induced by type I and type II interferons and contain multiple interferon (IFN)-stimulated response elements (ISREs) in their promoter regions. IFITM proteins play important roles in many cellular processes and their expression requires the presence of the chromatin remodeling SWI/SNF-like BAF complexes. Cellular processes involving IFITM proteins include cellular anti-proliferative activities and homotypic cell adhesion functions of interferons. In addition, IFITM genes are often upregulated in various cancer cells, suggesting a possible role in carcinogenesis. Localizing to the membrane, IFITM3 is a 133 amino acid protein that is induced by IFN-alpha and IFN-gamma. IFITM3 expression can be regulated by TEF-1, Brg-1 and Sp1.
仅用于科研。不用于诊断过程。未经明确授权不得转售。
篇参考文献 (0)
生物信息学
蛋白别名: 1-8U; Dispanin subfamily A member 2b; DSPA2b; Fragilis; Fragilis 3; Interferon-induced transmembrane protein 3; Interferon-inducible protein 1-8U; unnamed protein product
基因别名: 1-8U; DSPA2b; IFITM3; IP15
UniProt ID: (Human) Q01628
Entrez Gene ID: (Human) 10410